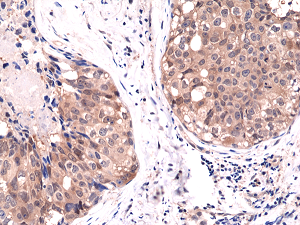
Anti-Akt1 (human), Rabbit Monoclonal (RM252)

Cookie-Einstellungen
Diese Website benutzt Cookies, die für den technischen Betrieb der Website erforderlich sind und stets gesetzt werden. Andere Cookies, die den Komfort bei Benutzung dieser Website erhöhen, der Direktwerbung dienen oder die Interaktion mit anderen Websites und sozialen Netzwerken vereinfachen sollen, werden nur mit Ihrer Zustimmung gesetzt.
Konfiguration
Technisch erforderlich
Diese Cookies sind für die Grundfunktionen des Shops notwendig.
"Alle Cookies ablehnen" Cookie
"Alle Cookies annehmen" Cookie
Ausgewählter Shop
CSRF-Token
Cookie-Einstellungen
FACT-Finder Tracking
Individuelle Preise
Kundenspezifisches Caching
Session
Währungswechsel
Komfortfunktionen
Diese Cookies werden genutzt um das Einkaufserlebnis noch ansprechender zu gestalten, beispielsweise für die Wiedererkennung des Besuchers.
Facebook-Seite in der rechten Blog - Sidebar anzeigen
Merkzettel
Statistik & Tracking
Endgeräteerkennung
Kauf- und Surfverhalten mit Google Tag Manager
Partnerprogramm
| Artikelnummer | Größe | Datenblatt | Manual | SDB | Lieferzeit | Menge | Preis |
|---|---|---|---|---|---|---|---|
| REV-31-1132-00-R100 | 100 µl | - | - |
3 - 9 Werktage* |
541,00 €
|
Bei Fragen nutzen Sie gerne unser Kontaktformular.
Bestellen Sie auch per E-Mail: info@biomol.com
Größere Menge gewünscht? Bulk-Anfrage
Bestellen Sie auch per E-Mail: info@biomol.com
Größere Menge gewünscht? Bulk-Anfrage
Recombinant Antibody. This antibody reacts to human Akt1. This antibody may also react to bovine,... mehr
Produktinformationen "Anti-Akt1 (human), Rabbit Monoclonal (RM252)"
Recombinant Antibody. This antibody reacts to human Akt1. This antibody may also react to bovine, mouse or rat Akt1, as predicted by immunogen homology. Applications: WB, IHC. Source: Rabbit. Liquid. 50% Glycerol/PBS with 1% BSA and 0.09% sodium azide. Akt, also referred to as PKB or Rac, plays a critical role in controlling survival and apoptosis. This protein kinase is activated at 2 phosphorylation sites Thr308 and Ser473. Akt promotes cell survival by inhibiting apoptosis through phosphorylation and inactivation of several targets, including Bad, forkhead transcription factors, c-Raf and caspase-9. In addition to its role in survival and glycogen synthesis, Akt is involved in cell cycle regulation. Akt also plays a critical role in cell growth by directly phosphorylating mTOR in a rapamycin-sensitive complex containing raptor. Mutation of the glutamic acid at residue 17 to lysine (E17K) of Akt was initially identified in human breast, colorectal and ovarian cancers. This conserved glutamic acid residue is located at the lipid-binding pocket of the Akt plextrin homology domain. The E17K mutation increases the affinity between Akt and phospholipids at the plasma membrane, leading to increased Akt recruitment, super-activation of the Akt pathway, cellular transformation and tumor formation. Additional studies detect the presence of the Akt (E17K) mutation in multiple cancers, including lung cancer, prostate cancer, endometrial carcinoma and several melanomas.
| Schlagworte: | PKB, AKT1, PKB alpha, EC=2.7.11.1, RAC-PK-alpha, Protein Kinase B, Proto-Oncogene c-Akt, Protein Kinase B alpha, PKBG, AKT3, STK-2, PKB gamma, RAC-PK-gamma, Protein Kinase Akt-3, Protein Kinase B gamma, AKT2, PKB beta, RAC-PK-beta, Protein |
| Hersteller: | RevMAb Biosciences |
| Hersteller-Nr: | 31-1132-00 |
Eigenschaften
| Anwendung: | WB, IHC |
| Antikörper-Typ: | Monoclonal |
| Klon: | RM252 |
| Konjugat: | No |
| Wirt: | Rabbit |
| Spezies-Reaktivität: | human |
| Format: | Purified |
Datenbank Information
| KEGG ID : | K04456 | Passende Produkte |
| UniProt ID : | P31749 | Passende Produkte |
| Gene ID : | GeneID 207 | Passende Produkte |
Handhabung & Sicherheit
| Lagerung: | -20°C |
| Versand: | +4°C (International: +4°C) |
Achtung
Nur für Forschungszwecke und Laboruntersuchungen: Nicht für die Anwendung im oder am Menschen!
Nur für Forschungszwecke und Laboruntersuchungen: Nicht für die Anwendung im oder am Menschen!
Hier folgen Informationen zur Produktreferenz.
mehr
Hier kriegen Sie ein Zertifikat
Loggen Sie sich ein oder registrieren Sie sich, um Analysenzertifikate anzufordern.
Bewertungen lesen, schreiben und diskutieren... mehr
Kundenbewertungen für "Anti-Akt1 (human), Rabbit Monoclonal (RM252)"
Bewertung schreiben
Loggen Sie sich ein oder registrieren Sie sich, um eine Produktbewertung abzugeben.
Zuletzt angesehen

